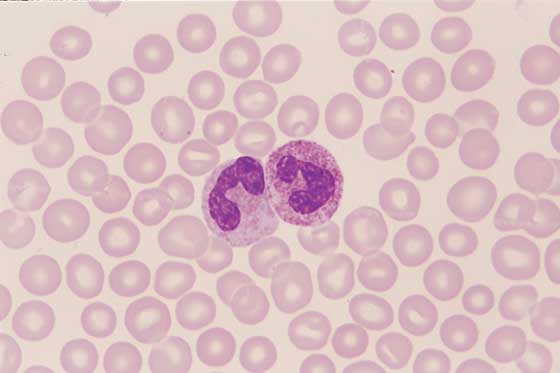

Nötrofiller ve Bağışıklık Sistemi: Enfeksiyonlara Karşı İlk Savunma Hattı
Bağışıklık sistemimiz, vücudumuzu zararlı mikroorganizmalara karşı koruyan karmaşık ve hayati bir savunma ağıdır. Bu ağın en ön saflarında yer alan kahramanlardan biri de nötrofillerdir. Bu yazımızda, bağışıklık sisteminin bu önemli bileşenleri hakkında temel bilgileri, kökenlerini, görevlerini, sayılarındaki değişimlerin (nötrofili ve nötropeni) anlamlarını ve toksik nötrofillerle ilişkili durumları detaylı bir şekilde inceleyeceğiz.
Nötrofiller: Bağışıklık Sisteminin Askerleri
Nötrofiller, beyaz kan hücreleri (lökositler) ailesinin önemli bir üyesidir ve tüm lökositlerin %30 ila %70'ini oluşturarak bağışıklık sistemimizin en kalabalık hücre grubunu temsil ederler. Özellikle bakteriyel enfeksiyonlara karşı vücudun ilk ve en etkili savunma mekanizmasını sağlarlar. Olgun nötrofiller, karakteristik segmentli çekirdek yapısına sahip oldukları için segmentli nötrofiller olarak da adlandırılırlar. Buna karşılık, genç ve henüz tam olarak olgunlaşmamış nötrofiller ise çubuk (band) çekirdekli nötrofiller olarak bilinirler.
Nötrofillerin Kökeni ve Kısa Yaşam Döngüsü
Nötrofiller, kemik iliğimizdeki özel öncü hücreler olan nötrofilik miyeloblastlardan köken alırlar. Bu karmaşık olgunlaşma süreci şu adımları içerir:
- Miyeloblastlar, bir dizi bölünme geçirerek önce progranülositlere, ardından miyelositlere dönüşürler.
- Miyelositler, daha da farklılaşarak metamiyelositler, bantlar (çubuk çekirdekli nötrofiller) ve nihayetinde olgun segmentli nötrofilleri oluştururlar.
- Bu üretim süreci, granülopoietin adı verilen önemli bir koloni uyarıcı faktör (CSF) tarafından sıkı bir şekilde kontrol edilir.
- Olgun nötrofillerin kemik iliğinden kana geçişi ise nötrofil-salgılatıcı faktör (NRF) tarafından düzenlenir.
Bir nötrofilin yaşam döngüsü oldukça kısadır. Kemik iliğinde yaklaşık 4 ila 8 gün boyunca gelişirler. Kana geçtikten sonra dolaşımdaki ömürleri ise ortalama 8 saat kadardır. Enfeksiyon bölgesindeki dokulara geçtikten sonra görevlerini hızla tamamlar ve ölürler. Bu kısa ömür, enfeksiyon bölgelerine sürekli olarak yeni nötrofil takviyesinin yapılmasını gerektirir.
Nötrofillerin Enfeksiyon Bölgelerine Göçü ve Fagositoz Mucizesi
Nötrofiller, enfeksiyonun olduğu bölgelere ulaşmak için sofistike bir dizi adımı izlerler:
- Kemotaksi: Enfekte olmuş bakteriyel hücrelerden veya hasar görmüş yangılı dokulardan salınan özel kimyasal sinyaller olan kemotaktik maddeler, nötrofilleri adeta bir mıknatıs gibi enfeksiyon bölgesine doğru çeker.
- Marjinasyon: Kan damarları içinde dolaşan nötrofiller, enfeksiyon bölgesine yakın damarların iç yüzeyini oluşturan endotel hücrelerine yapışır ve burada birikirler.
- Diapedez: Endotele yapışan nötrofiller, damar duvarındaki küçük boşluklardan geçerek kan damarlarının dışına, yani enfekte olmuş dokulara doğru hareket ederler.
- Amipsi Hareket: Dokulara geçen nötrofiller, amebaların hareketine benzer şekilde şekillerini değiştirerek enfeksiyonun yoğun olduğu bölgeye doğru ilerlerler.
Enfekte bölgeye ulaşan nötrofiller, vücudun en önemli savunma mekanizmalarından biri olan fagositoz yoluyla bakteri ve diğer zararlı mikroorganizmaları etkisiz hale getirirler. Fagositoz süreci şu şekilde gerçekleşir:
- Nötrofiller, hedef partikülleri (bakterileri, hasarlı hücreleri vb.) çevreleyerek kendi hücre zarlarıyla bir kese oluştururlar.
- Bu kese, fagositik vezikül (fagozom) olarak adlandırılan bir yapı içinde hedef partikülü hücrenin içine alır.
- Fagozom, lizozom adı verilen ve sindirici lizozomal enzimleri içeren hücre organelleriyle birleşir.
- Lizozomal enzimler, fagozomun içindeki zararlı maddeleri parçalayarak yok eder.
İnanılmaz bir şekilde, bir nötrofil ömrü boyunca yaklaşık 20 kadar bakteriyi fagosite edebilir. Bu yetenekleri, bakteriyel enfeksiyonların kontrol altına alınmasında hayati bir rol oynar.
Nötrofil Fonksiyonlarındaki Bozulmalar: Nötrofili ve Nötropeni
Nötrofil sayısındaki anormal artış veya azalış, bağışıklık sisteminin işleyişinde önemli sorunlara işaret edebilir.
Nötrofili: Nötrofil Sayısında Artış
Nötrofili, kanda segmentli nötrofil sayısında normalin üzerinde bir artış olarak tanımlanır. Nötrofiliye yol açabilen çeşitli nedenler vardır:
- Stres veya Heyecan: Vücudun stres veya heyecan durumlarında salgıladığı kortikosteroidler ve epinefrin gibi hormonlar, kemik iliğindeki nötrofillerin dolaşıma daha hızlı geçmesine neden olabilir.
- Enflamasyon (İltihap): Enfeksiyonlar veya doku hasarı sonucu ortaya çıkan enflamatuar sitokinler, kemik iliğini uyararak daha fazla nötrofilin kana salınmasına yol açar.
- Gecikmiş Apoptozis: Bazı faktörler, özellikle kortikosteroidler, nötrofillerin normal programlanmış hücre ölümü süreci olan apoptozunu geciktirerek dolaşımda daha uzun süre kalmalarına neden olabilir.
Nötropeni: Nötrofil Sayısında Azalış
Nötropeni, kanda nötrofil sayısında normalin altında bir düşüş ile karakterizedir ve vücudun enfeksiyonlara karşı savunma mekanizmasını ciddi şekilde zayıflatarak enfeksiyon riskini önemli ölçüde artırır. Nötropeniye neden olabilen çeşitli durumlar şunlardır:
- Kemik İliği Hastalıkları: Lösemi (kan kanseri) veya miyelofitizis (kemik iliğinin bağ dokusuyla yer değiştirmesi) gibi kemik iliğini etkileyen hastalıklar, nötrofil üretimini bozabilir.
- Viral Enfeksiyonlar: Feline lösemi virüsü (FeLV) veya parvovirüs gibi bazı viral enfeksiyonlar, kemik iliğini baskılayarak nötrofil sayısında düşüşe neden olabilir.
- Artan Yıkım: Otoimmün hastalıklar (vücudun kendi hücrelerine saldırdığı durumlar) veya toksik etkiler (ilaçlar, kimyasallar) nötrofillerin kanda daha hızlı yıkılmasına yol açabilir.
Toksik Nötrofiller ve Hastalık İlişkileri
Toksik nötrofiller, genellikle şiddetli inflamasyon (iltihap) veya toksemi (kanda toksin bulunması) durumlarında kan dolaşımında görülen anormal morfolojiye sahip nötrofillerdir. Bu hücrelerde mikroskop altında belirgin değişiklikler gözlemlenir:
- Sitoplazmik bazofili artışı: Nötrofilin sitoplazması normalden daha maviye boyanır.
- Köpüklü vakuolleşme: Sitoplazmada küçük, boşluk benzeri yapılar (vakuoller) oluşur.
- Dohle cisimcikleri: Sitoplazmada soluk mavi-gri renkli, küçük, granülsüz inklüzyonlar (hücre içi yapılar) bulunur.
Toksik nötrofillerin varlığı, vücutta ciddi bir inflamatuvar sürecin veya toksik bir durumun olduğunu gösterir ve inflamatuvar hastalığın şiddetini değerlendirmede önemli bir ipucu sağlar.
Sonuç: Nötrofiller Bağışıklık Savunmasının Temel Taşlarıdır
Nötrofiller, bağışıklık sistemimizin enfeksiyonlara karşı verdiği savaşın vazgeçilmez ve kritik bileşenlerindendir. Sağlıklı bir bağışıklık yanıtı için nötrofillerin uygun şekilde üretilmesi, enfeksiyon bölgelerine etkin bir şekilde göç etmesi ve fagositoz yeteneklerini kullanarak zararlı mikroorganizmaları yok etmesi hayati önem taşır. Nötrofili ve nötropeni gibi durumlar, bağışıklık sisteminin işleyişinde ciddi sorunlara işaret edebilir ve dikkatli bir şekilde değerlendirilmelidir. Özellikle toksik nötrofiller ve diğer morfolojik anormallikler, enfeksiyon ve inflamasyon süreçlerinin anlaşılması ve yönetilmesinde önemli bilgiler sunar.
Sıkça Sorulan Sorular (S.S.S)
- Nötrofiller ne kadar süre yaşar? Nötrofiller kemik iliğinde yaklaşık 4-8 gün, kan dolaşımında ise ortalama 8 saat yaşarlar. Dokulara geçtikten sonra görevlerini tamamlayarak ölürler.
- Nötrofili nedir? Nötrofili, kanda nötrofil sayısının normalin üzerinde olması durumudur ve genellikle enfeksiyon, stres veya inflamasyon gibi durumlarla ilişkilidir.
- Nötropeni neden tehlikelidir? Nötropeni, nötrofil sayısının azalması nedeniyle vücudun enfeksiyonlara karşı savunma mekanizmasını zayıflatır, bu da enfeksiyonlara karşı daha savunmasız hale gelmeye neden olur.
- Toksik nötrofiller hangi durumlarda görülür? Toksik nötrofiller, genellikle şiddetli inflamasyon (iltihap) veya toksemi (kanda toksin bulunması) gibi durumlarda ortaya çıkar.
- Nötrofiller fagositoz sırasında nasıl hareket eder? Nötrofiller, hedef partiküle (örneğin bakteri) bağlanır, onu çevreleyerek hücre içine alır ve daha sonra lizozomal enzimler kullanarak parçalayarak yok eder.
